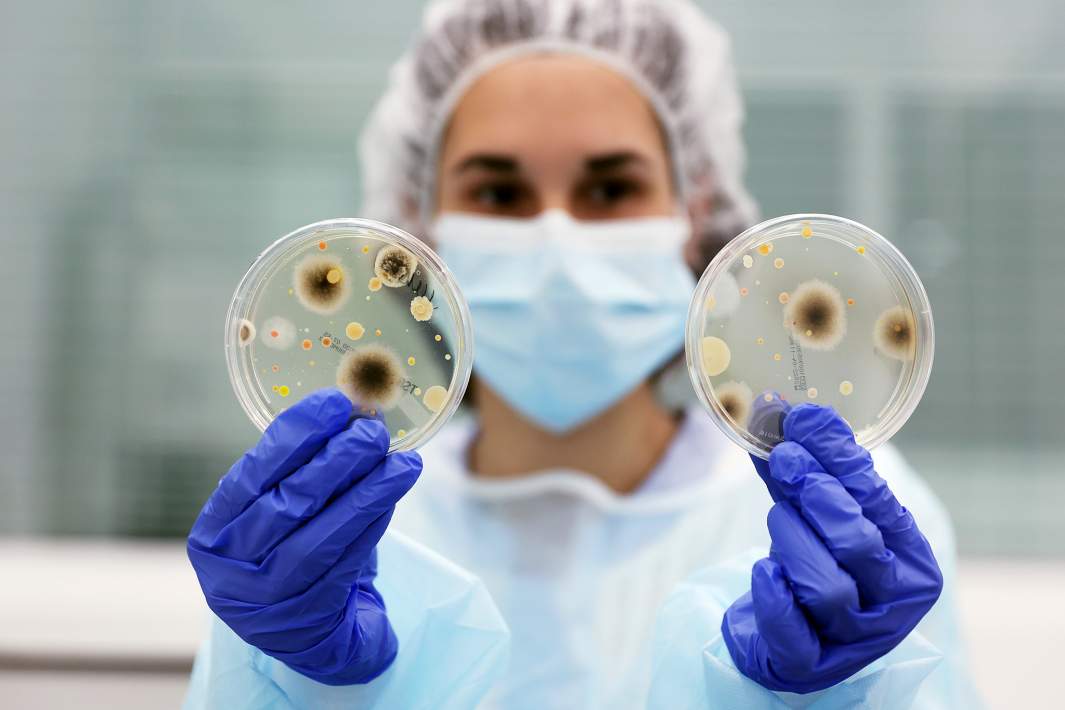
чашки петри
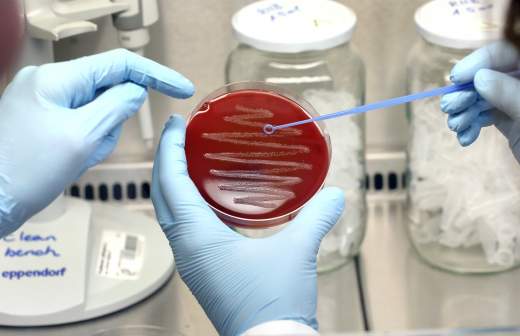

Вирусная отгрузка: наказание за контрабанду патогенов введут в УК

Ответственность за контрабанду патогенных биологических агентов, например вирусов и ядов, может появиться в Уголовном кодексе. Соответствующий законопроект поддержало правительство, хотя и с замечаниями, выяснили «Известия». Сейчас такой ответственности в УК нет, указали авторы инициативы: существующие формулировки слишком общие, что создает угрозу биологической безопасности страны, так как биоагенты могут использовать для терактов и диверсий. Но правительство полагает, что суды на практике все-таки могут счесть патогены опасными веществами, а те в Уголовном кодексе есть.
Защита от биотерроризма
Новый вид опасных веществ могут внести в статью УК о контрабанде. Речь идет о патогенных биологических агентах. Правительство поддержало, хоть и с оговорками, соответствующий законопроект, разработанный главой комитета Госдумы по безопасности Василием Пискаревым.
Патогенные биологические агенты — это, например, микроорганизмы, вирусы, белковоподобные инфекционные частицы, яды биологического происхождения. Такая формулировка содержится в законе «О биологической безопасности». Эти вещества созданы руками человека и способны вызывать патологические процессы в организме человека, животного или у растений. Закон отдельно уточняет, что опасность представляют и биологические материалы, в которых эти патогены могут содержаться.
Изменения предлагается внести в статью 226.1 УК — она предусматривает ответственность за контрабанду сильнодействующих, ядовитых, отравляющих, взрывчатых, радиоактивных веществ. Санкция по этой статье в зависимости от тяжести преступления — от 3 до 12 лет лишения свободы.
«Ответственность за незаконный ввоз в Россию и вывоз с ее территории патогенных биологических агентов в нарушение правил не установлено, — говорится в пояснительной записке к законопроекту. — Это создает прямую угрозу биологической безопасности, так как биоагенты могут быть использованы для осуществления терактов, диверсий и других преступлений».
Но правительство усомнилось, что судебная практика не учитывает патогенные биоагенты. В его отзыве указывается, что статья о контрабанде учитывает большой спектр опасных веществ.
«В материалах к законопроекту отсутствует информация о том, что к указанным веществам судебная практика не относит патогенные биологические агенты, а также предметы, способные вызывать патологический процесс в организме человека», — обращает внимание правительство, но указывает, что поправки поддерживает.
В судебной практике действительно можно встретить позицию, когда патогены обобщенно относят к запрещенным веществам, в частности, различным ядам, токсичным химикатам и так далее, подтвердил «Известиям» адвокат юридической фирмы «Инфралекс» Мартин Зарбабян.
— Любое изменение и дополнение существующих статей Уголовного кодекса не должно осложнять процесс квалификации, — сказал он.
Но член Ассоциации юристов России Ольга Турунина назвала целесообразным предложенное уточнение в УК.
— Она не охватывает биологические патогенные агенты, необходимо расширение перечня предметов, — сказала она. — Вследствие внесения изменений изменится и судебная практика, которая в настоящий момент не относит к предмету 226.1 (о контрабанде. — «Известия») вещества, имеющие биологическое происхождение.
Недостаток наказания
Также законопроект предполагает ужесточить наказание за нарушение правил безопасности при обращении с микробиологическими либо другими биологическими агентами или токсинами. Сейчас эта статья УК предполагает, что если оно стало причиной смерти человека, то наказание должно составить до пяти лет лишения свободы.
Поправки вводят новый состав — наказание за смерть двух и более лиц. Срок лишения свободы в этом случае будет уже до восьми лет лишения свободы.
И тут автор законопроекта вновь напоминает: понятие биологических агентов в этой статье сейчас не соответствует тому, которая содержится в ФЗ «О биологической безопасности». Но правительство и тут указало, что предметом преступления этой статьи патогены признаются.
В России и так достаточно жесткое законодательство, регламентирующее работу с патогенами, рассказала «Известиям» директор Института биологии и биомедицины ННГУ Мария Ведунова.
— Если вы занимаетесь даже микрофлорой полости рта, чем-то безвредным, всё равно вам нужно соблюдать множество разных правил, — сказала она. — И нужно, чтобы профильные организации имели возможность работать с вирусами и другими микроорганизмами, иначе они все станут режимными предприятиями.
По ее мнению, зачастую ужесточение законодательства может мешать развитию научных идей и созданию новых лекарственных средств.
— Однако если речь идет о смертельно опасных патогенах, то в данном контексте ужесточение ответственности — это нормально, лишь бы это не коснулось огромного количества лабораторий, которые просто работают с микроорганизмами и занимаются разработкой нужных всем направлений, — сказала Мария Ведунова.
Директор Научно-клинического центра прецизионной и регенеративной медицины Института фундаментальной медицины и биологии КФУ Альберт Ризванов добавил, что в сегменте официальных исследований и работы с патогенами контроль налажен.
— Есть перечень патогенов, входящих в разные группы, и в зависимости от них предъявляются требования к лабораториям и сотрудникам, — пояснил он «Известиям».
Но он признал, что основная проблема связана не с официальными исследованиями, а с тем, что недоброжелатели или биотеррористы могут работать с патогенами с террористическими целями или другими опасными намерениями.
— И таких примеров в истории много, когда намеренно заражали чумой, в том числе войска, или травили колодцы, — сказал он.
Ученый подчеркнул, что работа с патогенами требует меньших технических условий, чем с радиоактивными веществами. А тематика биотерроризма всё более актуальна, так как для таких вещей требуется меньше инфраструктурных вложений. И контролировать такие проекты очень сложно.
— То есть сварить что-то плохое можно даже у себя на кухне, — отметил Альберт Ризванов.
По его словам, это не будет оружием массового поражения, но можно создать патоген, который нанесет вред, в том числе смертельный, небольшой группе лиц.